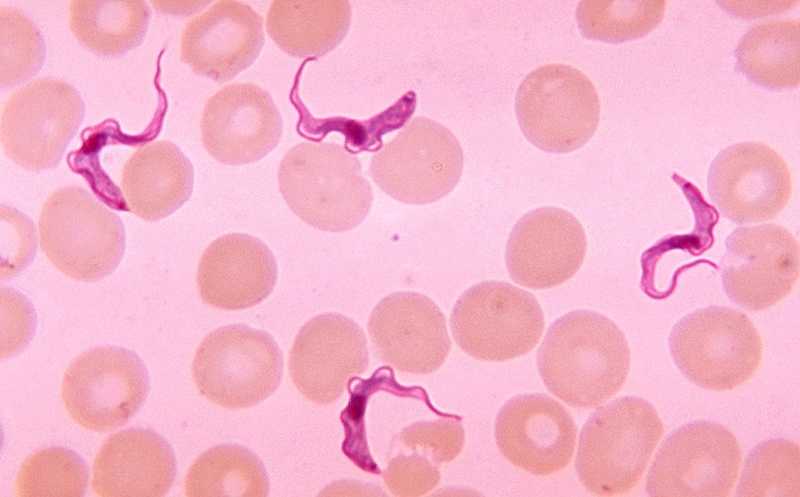

Потеря веса при сонной болезни замедляет размножение паразита
Международная группа авторов установила, что потеря жировой массы при инфицировании Trypanosoma brucei подавляет размножение паразита, так как продукты липолиза для него токсичны. Эксперименты на мышах показали, что в стимуляции липолиза во время трипаносомной инфекции играют важную роль Т- и В-лимфоциты: иммунодефицитные животные, зараженные трипаносомой, быстро умирали, но при этом медленнее теряли жир, чем контрольные.
wikimedia.org | CDC's Public Health Image Library
Одноклеточный паразит Trypanosoma brucei вызывает африканский трипаносомоз, или сонную болезнь. Переносчиком служат мухи цеце. На первой стадии у инфицированного появляются лихорадка, головная боль и боль в суставах, а через несколько недель или месяцев начинается вторая стадия — спутанность сознания, ухудшении координации движений, нарушения сна, а также сильная потеря веса; при отсутствии лечения возможен летальный исход. Клинические проявления болезни связаны с локализацией паразита, который может колонизировать и ЦНС, и кожу. Кроме того, T. brucei непропорционально накапливается в жировой ткани; предположительно, ее колонизация и иммунный ответ становятся причиной потери жировой массы. Авторы статьи, опубликованной в Nature Microbiology, продемонстрировали, что мыши с дефицитом фермента, расщепляющего липиды, погибали раньше контрольных животных, и что липолиз способствует накоплению свободных жирных кислот и ограничивает рост паразитов.
Липолиз в адипоцитах регулируется различными факторами, включая провоспалительные цитокины (например, TNF-α), сигналы симпатической нервной системы (например, норадреналин), гормоны (например, катехоламины или инсулин), а также компоненты бактериальной клеточной стенки (например, липополисахарид и пептидогликаны). Регуляция липолиза крайне важна для поддержания энергетического баланса в организме. У мышей крупнейшее депо висцерального жира — это жировая ткань гонад; она обеспечивает энергоснабжение половых органов и участвует в секреторной активности гонад.
Авторы исследования отбирали и взвешивали жировую ткань гонад у мышей, инфицированных T. brucei, в разные моменты после заражения. На 10-й день потеря массы составляла 30%, на 16-й — 54%, на 30-й — 65%. Таким образом, липолиз активируется на ранних стадиях заражения, и большая часть липидных запасов расходуется к 16-му дню. Активация липолиза в адипоцитах не была вызвана ни симпатической иннервацией (на нее не влияло химическое повреждение окончаний симпатических нейронов), ни потеря аппетита из-за болезни (контрольные мыши, получавшие столько же пищи, сколько съедали инфицированные, не демонстрировали высокого липолиза). Ключевым фактором оказалось присутствие Т-лимфоцитов и В-лимфоцитов. У иммунодефицитных мышей с дефектом гена активации рекомбинации 2 (Rag2-/-) Т- и В-клетки полностью отсутствуют. При инфекции T. brucei у них быстро развивается гиперпаразитемия, и обычно они погибают на 15-й день. Но потеря жировой массы у таких животных значительно ниже, чем у мышей с нормальной иммунной функцией.
Затем исследователи решили выяснить, как повлияет на инфекцию остановка липолиза в адипоцитах. Для этого использовали трансгенных мышей с адипоцитоспецифическим дефицитом жировой триглицеридлипазы (ATGL) — ключевого фермента липолиза. У этих мышей размер адипоцитов был более стабильным, и потеря массы жира при инфекции замедлилась. При этом через 10 дней после инфицирования в жировой ткани мышей с выключенным липолизом было в 10 раз больше паразитов, чем у мышей дикого типа, и умирали трансгенные мыши быстрее. Паразитарные нагрузки в печени, селезенке или легких обеих групп животных не различались: воздействие липолиза ограничивалось жировой тканью.
Интересно, что свободные жирные кислоты (СЖК), образующиеся в результате липолиза в жировой ткани, оказывают цитотоксическое воздействие на T. brucei. В экспериментах с совместным культивированием адипоцитов и трипаносомы увеличение концентрации СЖК подавляло рост паразитов. Анализ жидкостной среды в жировой ткани инфицированных мышей также выявил изменения в соотношениях СЖК, увеличивающие их токсичность для трипаносомы.
Авторы предполагают, что состав СЖК в жировой ткани способствует защите от трипаносомной инфекции. Это объясняет роль липолиза в организме инфицированных и открывает путь к новым терапевтическим стратегиям.
Истощение скелетных мышц помогает бороться с паразитической инфекцией
Источник
Machado, H., et al. Adipocyte lipolysis protects mice against Trypanosoma brucei infection // Nature Microbiology (2023). DOI: 10.1038/s41564-023-01496-7


 Меню
Меню





 Все темы
Все темы




 0
0












